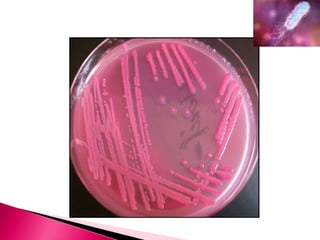

Embed presentation
Downloaded 24 times















This document discusses different culture techniques used to isolate and grow bacteria, including streak culture, lawn culture, stroke culture, stab culture, and pour plate method. Streak culture is used to isolate single colonies on a plate by streaking inoculum in parallel lines. Lawn culture provides uniform surface growth by flooding the plate. Stroke and stab cultures grow bacteria in agar slopes or slants for diagnostic tests or maintaining stock cultures. Pour plate method mixes inoculum into molten agar before pouring to quantify bacterial counts.